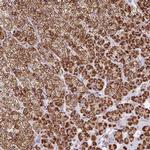
FDX1 Antibody in Immunohistochemistry (IHC)

Search
Invitrogen
FDX1 Polyclonal Antibody
{{$productOrderCtrl.translations['antibody.pdp.commerceCard.promotion.promotions']}}
{{$productOrderCtrl.translations['antibody.pdp.commerceCard.promotion.viewpromo']}}
{{$productOrderCtrl.translations['antibody.pdp.commerceCard.promotion.promocode']}}: {{promo.promoCode}} {{promo.promoTitle}} {{promo.promoDescription}}. {{$productOrderCtrl.translations['antibody.pdp.commerceCard.promotion.learnmore']}}
产品信息
PA5-64002
种属反应
宿主/亚型
分类
类型
抗原
偶联物
形式
浓度
规格
纯化类型
保存液
内含物
保存条件
运输条件
RRID
产品详细信息
Immunogen sequence: WLHHAGSRAG SSGLLRNRGP GGSAEASRSL SVSARARSSS EDKITVHFIN RDGETLTTKG
Highest antigen sequence identity to the following orthologs: Mouse - 61%, Rat - 61%.
靶标信息
The product of this gene is a small iron-sulfur protein that transfers electrons from NADPH through ferredoxin reductase to a terminal cytochrome P450. This particular oxidation/reduction system is found in steroidogenic tissues, and is involved with the synthesis of bile acid and vitamin D. In addition to the expressed gene at this chromosomal locus (11q22), there are pseudogenes located on chromosomes 20 and 21. This gene product has been identified in a number of different tissues but all forms have been shown to be identical and are not tissue specific.
仅用于科研。不用于诊断过程。未经明确授权不得转售。
篇参考文献 (0)
生物信息学
蛋白别名: Adrenal ferredoxin; Adrenodoxin, mitochondrial; ferredoxin; Ferredoxin-1; Hepatoredoxin; mitochondrial adrenodoxin
基因别名: ADX; FDX; FDX1; LOH11CR1D
UniProt ID: (Human) P10109
Entrez Gene ID: (Human) 2230